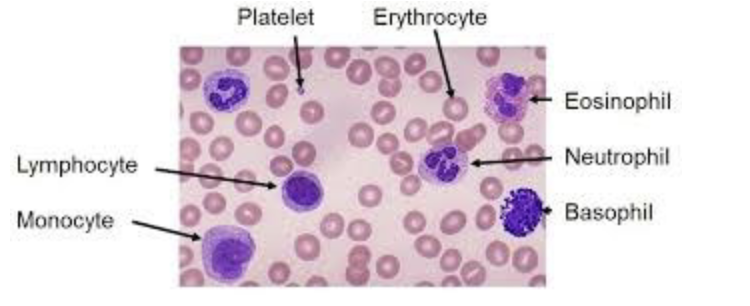
<ul><li><p><span>Normal neutrophil turnover in an average adult is on the order of 10^11 cells per day.</span></p></li><li><p><span>Humans and mice differ in their numbers of circulating neutrophils. In humans, 50–70% of circulating leukocytes are neutrophils, whereas only 10– 25% are in mice.</span></p></li><li><p><span>In the circulation, mature neutrophils have an average diameter of 7–10μm, their nucleus is segmented and their cytoplasm is enriched with<br>granules and secretory vesicles.</span></p></li></ul><p>neutrophils= provide constant support (ready to fight)</p><p>-need constant supply, sufficient supply to respond to infection</p><p>-turnover trillions of cells a day -v. active process</p><p>-short lived</p><p>above 70% circulating= infection</p><p></p>

1/68
Looks like no tags are added yet.
Name | Mastery | Learn | Test | Matching | Spaced | Call with Kai |
|---|
No analytics yet
Send a link to your students to track their progress
What is immunometabolism?
the study of interactions between immune and metabolic pathways
Who first theorized immunometabolism?
1883 by Elie Metchnikoff
Metchnikoff father of immunology (identified phagocytosis)
noticed that adipose tissues macrophages were particularly inflammatory
What is the connection between immunity and metabolism?
Inflammation and immune responses control systemic metabolism & Metabolic changes impact differentiation, activation, and regulation of the immune cells.
How many major metabolism pathways have been studied in immune cells? What are they?
glycolysis, the tricarboxylic acid (TCA) cycle, the pentose phosphate pathway, fatty acid oxidation, fatty
acid synthesis and amino acid metabolism
Which metabolism pathways are key features of LPS-activated macrophages?
Glycolysis and fatty acid synthesis are key features of lipopolysaccharide (LPS)-activated macrophages; by contrast, upon anti-inflammatory signaling (e.g. IL-4 stimulation), macrophages use oxidative phosphorylation and fatty acid oxidation
macrophages switch from glycolysis to oxidative phosphorylation and fatty acid oxidation to manipulate the passage from anti-inflammatory to inflammatory
___ T cells are highly glycolytic whereas ____ T cells have an oxidative metabolism
Effector → highly glycolytic
Memory→ oxidative metabolism
What metabolites have roles outside of metabolism that promote specific events during immune cell activation?
succinate and citrate, and enzymes, such as pyruvate kinase isoenzyme M2 (PKM2), glyceraldehyde 3-phosphate dehydrogenase (GAPDH) and enolase, have roles outside of metabolism that promote specific events during immune cell activation
How can small molecules target metabolic pathways? What is the outcome?
Small molecules can target metabolic pathways and alter the phenotype of immune cells, raising the possibility to use them to develop novel therapeutic intervention in immune diseases
In the past 10 years or so is something of a rediscovery of metabolism by immunologists and the emergence of what is now termed the field of immunometabolism. Why did this happen?
Advances in immunology, including the discovery of whole new immune receptor systems (most notably the pattern recognition receptors (PRRs)), the description of many cytokines and immune cell types, led to a deeper understanding of the development and molecular regulation of these immune cells.
The application of newer tools and approaches (such as techniques that measure the flux through metabolic pathways) to the study of the immune system, provided scientists with exciting new insights into the core of what is happening during an immune response. That core involves complex and specific metabolic changes that directly connect to those aspects of immunity and host defence.
What is the definition of a metabolic pathway?
The growth and maintenance of a cell through its catabolic and anabolic processes that generate energy has long been viewed as the main, if not the only, function of cellular metabolic pathways.
Now we know that specific metabolic networks control immunological effector functions in
immune cells.
These metabolic pathways, although diverse in terms of their end products, are closely linked as a consequence of shared fuel inputs, and a reliance on products from one pathway to feed into alternative pathways as key synthetic precursors (e.g. fatty acids synthesis)
What is glycolysis?
begins with the uptake of extracellular glucose from the environment surrounding the cell and subsequent intracellular processing of glucose in the cytosol to eventually yield pyruvate along with numerous other product
relatively inefficient pathway for the generation of
cellular ATP, giving only two molecules of ATP per unit of glucose. However, glycolytic metabolism provides key benefits to cells because it also allows for the reduction of NAD+ to NADH, which
is used by numerous enzymes as a cofactor
provides intermediated for the synthesis of
nucleotide (ribose), fatty acids (pyruvate for the TCA cycle) and amino acids
What is the product of glycolysis?
process in every cell
starts chain of reaction once glucose is present
makes 2ATP from 1 glucose
makes NADH (cofactor for fuelling enzymatic reactions in cell)
makes pyruvate

What is the pentose phosphate pathway?
The pentose phosphate pathway allows the diversion of intermediates from the glycolytic pathway towards the production of nucleotide and amino acid precursors that are necessary for cell growth and proliferation
generation of reducing equivalents of NADPH, which has an important role in the maintenance of a favourable redox environment in the cell

What is the TCA pathway?
Occurs in the matrix of the mitochondrion and is a major metabolic pathway used in most quiescent or non-proliferative cell settings.
The TCA cycle is a nexus for multiple nutrient inputs. Most notably, glucose-derived pyruvate or fatty acids are converted into acetyl coenzyme A (acetyl-CoA) that joins the TCA cycle. Glutamate is also a critical fuel for the TCA cycle.
Two major products of the TCA cycle are NADH and FADH2, which can transfer electrons to the electron transport chain to support oxidative phosphorylation and highly efficient ATP generation
just know that in red
just know glycolysis: glucose→ acetyl CoA (fuel for TCA -made from pyruvate)
alpha-ketoglutarate: essential to make anti-inflammatory molecule and important for a.a production

How does glycolysis connect to other metabolic pathways?
Glucose uptaken form extracellular environment makes pyruvate (can go to mitochondria-TCA or Glycolysis) pentose phosphate pathway G-6-P can be used to make ribose and used for nucleotide synthesis (needed for cell proliferation and growth)
know general glycolysis and PPP and know which molecules involved in the two and how they connect

What is Fatty acid oxidation?
The fatty acid oxidation pathway allows for the mitochondrial conversion of fatty acids into numerous products that the cell can further use to generate energy, including acetyl-CoA, NADH and
FADH2.
Fatty acid oxidation initiates in the cytosol via an enzyme-mediated to generate a fatty acid acyl-CoA. Once Fatty acid acyl-CoA is produced β-oxidation of the long and medium fatty acid acyl-CoA commences in the mitochondria, yielding large amounts of acetyl-CoA, that will be further used in the TCA cycle.
β-oxidation is inhibited when high fatty acids synthesis is occurring in a cell.
cytoplasm made to fatty-acyl-CoA (can then pass through the membrane)
know the steps summarized (above)

What metabolic pathways are needed to maintain lipids in the cell?
fatty acid Beta oxidation and fatty acid synthesis are needed to maintain lipid amount in cells
What are the features of fatty acid synthesis?
The fatty acid synthesis pathway allows cells to generate lipids that are necessary for cellular growth and proliferation from precursors derived from other cell intrinsic metabolic pathways.
Synthesis of straight chain fatty acids, TCA cycle derived citrate may be exported from the mitochondria into the cytosol via the citrate carrier, where are converted into acetyl-coA. The acetyl-
CoA derived from this process may then be used by ACC to yield malonyl-CoA. Subsequently, FASN elongates the nascent fatty acid chain until products such as palmitic acid are synthesized. Fatty acids with alternative chain lengths may be
synthesized using palmitic acid as a substrate for further elongation
FASN fatty acid synthesis enzyme
citrate is made in mitochondria leaves mitochondria and is in cytoplasm: used to make Manoyl-CoA
→used with acyl to make Malonyl-CoA which enters the fatty acid synthase cascade =16C palmatate (make membrane lipids, phospholipids, longer chains, …)
just know what is mentioned (above)

What are the features of the synthesis of amino acids?
Amino acids are building blocks in protein synthesis
Amino acids can act as precursors for the de novo synthesis of branched-chain fatty acids.
Individual amino acids may play more specific roles in metabolic pathways. For instance, glutamine and aspartate are required for de novo purine and pyrimidine synthesis
purine + pyrimidines= building blocks of DNA
one metabolic can make metabolites for another
glycolysis supplies a lot of intermediates so does TCA

What are the features of glycolysis in immune cells?
Enhanced glycolysis occurs in lipopolysaccharide (LPS)-activated macrophages and DCs, in activated natural killer (NK) cells, in activated effector T cells and in activated B cells
Effector T cell subsets all show an increase in glycolysis following activation, most notably T helper(TH17) cells, TH1 and TH2 cells and activated effector CD8+ T cells
Glycolysis is important for the activation of immune cells.
glycolysis supplies metabolites or enzymes that are made have regulatory functions of immune cells
Increased glycolysis can therefore be considered a hallmark metabolic change in most immune cells undergoing rapid activation in response to stimulation of PRRs, cytokine receptors or antigen receptors
For macrophages this includes phagocytosis and inflammatory cytokine production,
for DCs this includes antigen presentation and for T cells this includes the production of effector cytokines (such as IL-17 in the case of TH17 cells).

What are the features of glycolysis in Th1 cells?
TH1 cells it has been shown that GAPDH binds to mRNA that encodes interferon-γ (IFNγ) repressing its translation. Once glycolysis is triggered, however, GAPDH dissociates from IFNG mRNA, allowing it to be translate

What are the features of glycolysis in macrophages?
In macrophages, another glycolytic enzyme, hexokinase 1, has been shown as an NLRP3 (NOD-, LRR- and pyrin domain-containing 3) regulator. The NLRP3 inflammasome is a crucial regulator of caspase 1, which generates mature IL-1β, as well as active IL-18, and induces a type of cell death called pyroptosis. Evidence has been presented that hexokinase interacts with NLRP3 in the outer mitochondrial membrane, enabling NLRP3 activation

What is the role of the pentose phosphate pathway in immune cells?
Pentose phosphate pathway is involved in nucleotide production (which happens during cell proliferation) and NADPH production
NADPH has multiple functions in immune cells. It is used by the NADPH oxidase to generate reactive oxygen species (ROS) during the respiratory burst, but as a counter-balance it is also used to generate glutathione and other antioxidants
The pentose phosphate pathway has been shown to be elevated in LPS-activated macrophages. A key control point is the enzyme carbohydrate kinase-like protein (CARKL). This enzyme limits the flux through the pentose phosphate pathway, and it has been shown to be highly expressed in M2 macrophages. If CARKL is suppressed, macrophages become M1-like, indicating the importance of the pentose phosphate pathway for M1 macrophage function.
respiratory burst are bacteriacide and need to be balanced as to not kill the cell itself so needs to make glutathione which controls and manages the oxidative bursts
What are the difference of the TCA cycle in M2 macrophages and M1?
TCA cycle in distinct macrophage subtypes. In M2 macrophages, there is an intact TCA cycle that is
coupled to oxidative phosphorylation.
In M1 macrophages, TCA cycle has been shown to be broken in two places — after citrate and after
succinate
Succinate that accumulates in M1 macrophages as a consequence of a broken TCA cycle has a direct impact on macrophage cytokine production. One mechanism involved is the stabilization of HIF1α and the sustained production of the inflammatory cytokine IL-1β
in immune cells two types of TCA cycles (not happening in same cells at same time)
broken TCA seen in activated macrophages
broken cycle bc TCA cycle cannot complete= high abundance of citrate accumulation→ fatty acid production = cell proliferation
itaconate production is typical of activated macrophage

What is the role of the TCA cycle in immunity?
TCA is fully functional in most T cell subsets, although, there is a shift towards glycolysis and away from the TCA cycle in effector T cells.
TCA cycle is very prominent in memory CD8+ T cells.
Increased citrate boost fatty acids synthesis for membrane biogenesis that is important for antigen
presentation and phagocytosis
Excess citrate can also feed into pathways that generate nitric oxide and prostaglandins, which are
key effector inflammatory molecules made by macrophages
A third metabolite generated from citrate is itaconic acid, which has been shown to have direct
bactericidal effects on species such as Salmonella enterica subsp. enterica serovar Typhimurium
and Mycobacterium tuberculo The TCA cycle in immunity
What is the role of fatty acid oxidation in immunity?
Fatty acid oxidation has key roles in the regulation of adaptive and innate immune responses
Fatty acid oxidation has been observed in many immune cells that are not inflammatory in nature and exhibit increased cellular lifespans, including M2 macrophages, Treg cells and memory T cells
Treg cells exhibit increased fatty acid oxidation relative to TH1, TH2 and TH17 cells and fatty acid oxidation promotes the generation of Treg cells while inhibiting effector T cell polarization
Memory CD8+ T cells, which slowly proliferate under steady state conditions but allow for a rapid innate immune response to previously encountered
antigens, appear to require fatty acid oxidation to respond to antigen stimulation in a timely manner
FAO supports inflammatory types, Tregs, M2 macrophage, supports toleregenic stimuli which leads to production of suppressive cytokines = creation of tolerance become memory cells

What is the role of fatty acid synthesis in immunity?
Fatty acid synthesis seems to positively regulate the generation and function of pro-inflammatory immune cells of both the innate and adaptive immune systems
LPS and cytokines trigger an increase in fatty acid synthesis in macrophage
Fatty acid synthesis was found to be upregulated during Toll-like receptor (TLR)-mediated DC activation, and this increased fatty acid synthesis was necessary for DC activation and their stimulation of CD8+ T cell responses
Fatty acid synthesis is also key to the cell intrinsic function of T cells and B cells; synthesis of fatty acids and sterols has been shown to be necessary for cell proliferation after the activation of these cells through their antigen receptors
FAS is active in effector T cell and activated innate immune cell supports inflammatory stimuli leads to proliferation of cytokines

What is the link between amino acid metabolism and immune function?
*image
Amino acid metabolism plays an important role in mediating functionality of the innate and adaptive immune cells.
In macrophages, the amino acids glutamine and arginine are crucial for immune functions including cytokine and nitric oxide production
The fate of arginine in macrophages is a key distinction between inflammatory and tolerant cell phenotypes:
Arginine has inflammatory involvement in the nitric oxide synthesis pathway, while arginine flux through the arginase pathway is associated with a more tolerant immune response, often associated with wound healing
Tryptophan metabolism by macrophages may suppress the activity of the adaptive immune system.
In T cells, glutamine and arginine promote robust responses to T cell receptor (TCR) stimulation, including proliferation and cytokine production
Tryptophan has an important role in promoting T cell proliferation, and lack of it may mediate failure to respond to infections or tumours

What are the features of metabolism of the immune cell subtypes?
*image
The various immune cell subsets exhibit a reliance on distinct metabolic pathways to promote cell survival, lineage generation and function.
M2 macrophages, which exhibit a more tolerant phenotype, use the TCA cycle, fatty acid oxidation and arginine flux into the arginase pathway.
Rapidly proliferating effector T cells, including T helper 1 (TH1), TH17 and cytotoxic CD8+ T cells, use glycolysis, fatty acid synthesis and amino acid metabolism to promote proliferation and cytokine production.
Immunosuppressive regulatory T (Treg) cells use the TCA cycle and fatty acid oxidation.
memory CD8+ T cells also require the use of the TCA cycle and fatty acid oxidation to promote increased cell lifespan. ROS, reactive oxygen species.

What are the features of immunometabolism?
IL-4 (anti-inflammatory) often secreted by parasites to try and stop the reaction it is an activator for TCA and oxidative phosphorylation, makes cells more anti-inflammatory
danger signals activate transcription signal HIF1alpha → pathways → metabolites made that are essential for biomolecules needed for inflammatory and immune response

What is the role of the peroxisome in immunity?
pathway that occurs in peroxisome
the metabolism of this organelle is very important to modulate immune cell function and behaviour

What is the role of mitochondria in immunity?
regulation of metabolites that are immune stimulating
ex: ROS
research into this is allowing the discovery of new potential targets in health and disease

What are the features of immunometabolism in disease and translation?
Ultimate goal of immunometabolism is to exploit the specific metabolic programs of distinct immune cell populations to treat disease
Example: In systemic lupus erythematosus (SLE) the metabolism of T cells, B cells, and DCs that contribute to SLE have been shown to be highly glycolytic
Metabolic inhibitors for glycolysis and alternate metabolic pathways now offer new directions with successful preclinical proof of principle studies, and it is now important to move to human clinical trials to combat this auto-immune disease
research normally targeting enzymes hexokinase, GAPDH, PK M2

What are the three components of innate immunity?
Anatomical barrier
-Physical barrier
-Chemical barrier
Cell
-Phagocytic cell
-Dendritic cell
-NK cells, ILC
Soluble proteins
-Complement
-Cytokines, Chemokines
-Anti-microbial substances

What cells are phagocytes?
Neutrophil
DC
Macrophage
Monocyte
neutrophils + macrophage= critical innate cells

What are the features of neutrophil development?
Haematopoietic stem cells (HSC) → Haematopoietic progenitor cells → Mature Haematopoietic cells
are part of the myeloid lineage

What is the quantity, size and morphology of neutrophils?
Normal neutrophil turnover in an average adult is on the order of 10^11 cells per day.
Humans and mice differ in their numbers of circulating neutrophils. In humans, 50–70% of circulating leukocytes are neutrophils, whereas only 10– 25% are in mice.
In the circulation, mature neutrophils have an average diameter of 7–10μm, their nucleus is segmented and their cytoplasm is enriched with
granules and secretory vesicles.
neutrophils= provide constant support (ready to fight)
-need constant supply, sufficient supply to respond to infection
-turnover trillions of cells a day -v. active process
-short lived
above 70% circulating= infection
What are the features of innate cells?
innate cells: distinct morphology- stained lymphocytes have small cytoplasm, neutrophils are distinctive bigger than lymphocytes and they have segmented nucleus (polymorphal nucleus cells)
Is bone marrow granulopoiesis affected during local infection?
Bone marrow granulopoiesis is unaffected during
local infection
neutrophils macrophages destroy pathogens when exposed to bacteria from cut the rest of body will not react
under normal conditions bone marrow granulopoiesis is constant and maintains the stable balance of granulocytes

When is emergency granulopoiesis initiated?
Emergency granulopoiesis is initiated in response to
the increased demand
bone marrow called in for help
if local infection is severe and consumption of neutrophils is large, needs more cells→ bone marrow will increase neutrophils production
largely controlled by IL-17 (upregulated and feedback to bone marrow epithelial cells and pump out GCSF which induces granulopoeisis)

What are the features of granulocytic maturation?
six stages of neutrophils in the bone marrow
could have some band neutrophils in peripheral blood but if the previous types appear this is a problem
important change: granules (dots)- three or four different types
cell size decreases
nuclear volume generally decreases
nuclear maturation goes from round, fine chromatin to segmented, dark chromatin
nuclear-to-cytoplasmic ratio decreases
no cytoplasmic granules to primary (azurophilic) granules to specific (secondary granules)
What are the features of neutrophil granules during different stages of granulocytic maturation?
granules appear in neutrophils at different stages
azurophilic: distinct blue or purple colour (stops at promyelocyte stage)
gelatinase: marker used to indicate mature neutrophils also known as MMP9
need for different types of granules: have their own biological functions

What is the process of Neutrophil Recruitment to Sites of Inflammation
Done through Extravasation
when neutrophils are activated
resting condition they are circulating (always checking the blood vessels)
sensing for chemokine gradient (IL-8) sense complement product, leukotrines (lipid mediators)
neutrophils will respond to these signals that are chemoattractant
endothelial capture the neutrophils
integrin dependent rolling process
firm adhesion
transmigrate into the tissue site
when in the tissue site will do their job: phagocytosis→ degranulations and cytokine secretion, releasing NETs (neutrophil content)
-defense mechanism

What are the different killing mechanisms?
Phagocytosis: Neutrophils ingest microorganisms into a phagosome, which then merges with granules (degranulation) to kill the pathogen internally.
Degranulation: Activated neutrophils release cytoplasmic granules (containing antimicrobial peptides like defensins) into the extracellular space to destroy bacteria.
Neutrophil Extracellular Traps (NETs): A, often terminal, process where neutrophils release their decondensed chromatin DNA, coated with histones and antimicrobial proteins (e.g., myeloperoxidase, neutrophil elastase). These traps catch and kill bacteria, fungi, and parasites outside the cell.

What are the steps of phagocytosis?
Pseudopodia→ phagososme→ fuses with lysosome→ lysosomal enzymes → released from cell

What is required for initiation of neutrophil phagocytosis?
Initiation of neutrophil phagocytosis requires decoration of bacteria with opsonins
Major opsonin:
Lectin
C3b
IgG
if there is bacteria and complement is attached (type of opsonin that can deposit onto the bacteria)
antibody IgG coats the bacteria
on neutrophils they have multitude of receptors that can bind to the opsonins

What induces phagocytosis (direct vs indirect)?
Phagocytosis may be induced directly through PRRs recognition or indirectly through opsonin recognition

What is the oxidative killing mechanism?
A strong oxidative burst is concurrently initiated in the phagosome by NADPH-oxidase upon triggering of specific cell surface receptors, leading to the generation of highly toxic ROIs.
reactive oxygen production
What are the features of the NADPH oxidase system?
A GTPase plus five phagocytic oxidase
Activated by:
C5a
FMLP
LTB4
PAF
TLRs
Chemokine Rs

What is the respiratory burst? What cells does this occur in?
The respiratory burst in macrophages and neutrophils is caused by a transient increase in oxygen consumption during the production of microbicidal oxygen metabolites.

What is Chronic Granulomatous Disease (CGD)
• Mutation in gp91 (x-linked CGD)
• Mutation in p47 (autosomal recessive)
• characterized by recurrent life-threatening infections, hypergammaglobulinemia and tissue granuloma formation.
• Infections are most commonly pneumonia, lymphadenitis, liver abscess, skin abscess, perianal abscess, and osteomyelitis.
Superoxide production by activated PMNs assayed by
nitroblue tetrazolium dye reduction (NBT)

What are the 3 Mechanism of Action of Neutrophil Antimicrobial Proteins?
Cationic antimicrobial peptides
Proteolytic enzymes
Metal chelator proteins
What are the cationic antimicrobial peptides?
-Mechanism of action of neutrophils against antimicrobial proteins
α-defensins: Permeabilize membrane bilayers containing negatively charged phospholipids; Inhibit DNA, RNA as well as protein biosynthesis; Inhibition of bacterial cell wall synthesis.
LL-37: Transmembrane pore-forming.
BPI: Increase bacterial permeability and hydrolysis of bacterial phospholipids by binding to LPS
What are the proteolytic enzymes?
-Mechanism of action of neutrophils against antimicrobial proteins
Lysozyme: Degrades bacterial cell wall;
Proteinase 3 (PR3): contributes to the proteolytic generation of antimicrobial peptides;
Neutrophil elastase (NE): is critically required for controlling gram-negative bacterial but not gram-positive bacterial growth
Cathepsin G (CG): Cleaves bacterial virulence factors and outer membrane proteins;
Azurocidin: also known as cationic antimicrobial protein CAP37 or heparin-binding protein
What are the metal chelator proteins?
-Mechanism of action of neutrophils against antimicrobial proteins
Lactoferrin: Alters bacterial growth by binding to iron, an essential bacterial nutrient. Binds to the lipid A part of LPS, causing a release of LPS from the cell wall and an increase in membrane permeability;
Calprotectin: Alters bacterial growth by sequestering
magnesium and zinc
What happens to mice when they are deficient in neutrophil elastase (NE)?
Mice deficient in neutrophil elastases are more prone
to develop Gram-negative bacterial infections
mice w/ elastase need 50 000 bacteria to kill but without need 3000
survival curve drops without the elastase
Neutrophil Elastase is critically required for controlling gram-negative bacterial but not gram-positive bacterial growth

What type of infections are likely to occur in mice deficient in cathepsin G?
more susceptible to Gram-positive bacterial infections
KO means knockout
elastase knockout is okay in gram+
but if not cathepsin (handle respiratory burst) struggles to maintain cell survival
intracellular relies more on non-oxidative that the gram-negative needs

What type of bacteria does NE control?
Neutrophil Elastase is critically required for controlling gram-negative bacterial but not gram-positive bacterial growth
Transmission electron microscopy of wild-type and neutrophil elastase-deficient neutrophils two hours after
infection with K. pneumoniae

What are the features of Neutrophil extracellular traps (NET)?
In inflammatory conditions, neutrophils release intracellular structures composed of chromatin DNA, histones and granular proteins into the extracellular environment, these structures are known as neutrophil extracellular traps (NETs).
The obvious function of web-like structures would be trapping pathogens.
NETs are covered in potently antimicrobial histones, enzymatically active MPO and proteases.
in the neutrophil tract: a lot of genomic DNA, it is sticky and forms a net that has a lot of proteases and these molecules stick to the chromatin structure
and can trap the bacteria- sacrifice from neutrophils releases this net
good and bad aspects of making the trap

What are some functional roles of neutrophils (other than it’s killing mechanisms)
Neutrophils communication with other immune cells
also able to communicate, a lot of cross-talk between neutrophils and marginal zone B cell, bc neutrophils make a lot of cytokines, BAFF, APRIL, IL-21
marginal B zone dump a lot of antibodies
neutrophils after net formation have other cells plasma dendritic cells that take up the net for other process
goes to draining lymph nodes and talks with T cell and NK cells
oxidative killing goes together w/ phagocytosis know these are the killing mechanisms of neutrophils

What is bad thing that can happen with NETs (traps)?
when extracellular trap is formed:
-cause tissue pathology when there is too much
there is a balance

How would you visualize NETs in cells?
use antibodies to look at the MPO and look at localization
trap= localization
MPO released by NETs

What are the features of Neutrophils vs. MDSCs?
in cancer fields -FYI
during acute infection or chronic when body needs bone marrow constantly producing neutrophils can have an imbalance and body cannot meet the demand and will send immature cells
the immature neutrophils in the cancer literature is described as unique type of suppressive cells have surface markers similar to neutrophils
MDSCs produces iNos, Arginase, it is mediated through metabolic competition

How do neutrophils meet their end?
Efferocytosis: ingestion of the dying neutrophil by macrophages.
Necroptosis: is propagated by RIPK1/RIPK3/RHIM axis, which leads to the phosphorylation of the pore-forming protein MLKL, and the formation of necrosome (also known as ripoptosome). Phosphorylation of MLKL by the necrosome prompts MLKL oligomerization, enabling MLKL to insert into and permeabilize the plasma membrane.
Pyroptosis: is mediated by caspase-1-dependent cell death. The membrane pores are sized sufficiently to allow the release of soluble cytosolic contents only, retaining larger bacteria and organelles intracellularly. It is mediated by IL-1b, IL-18 and eicosanoids.
NETosis: formation of networks of extracellular fibers, primarily composed of DNA from neutrophils and proteins that bind pathogens.
mostly mediated by macrophages they recognize apoptotic body and clean it in normal conditions
elevated chronic inflammation with age as this process becomes less efficient
after infection resolved
distinct molecular pathway that helps to kill the neutrophils through necroptosis (not apoptosis)
pyroptosis during inflammasome (anti-inflammatory)
Netosis is inflammatory
the way neutrophils die will dictate body condition

What are the features of macrophage differentiation? (two options)
The majority of tissue macrophage populations are seeded before birth and maintained via self-proliferation throughout adulthood with minimal monocyte input
macrophages have two origins
some macrophages are from birth: come from embryonic stage they are seeded into the different organs= tissue resident macrophages
bone marrow derived macrophage: rate of this process is slow but during infection it will accelerate

What are the human receptors that trigger phagocytosis?
C-type lectin: Mannose receptor, Dectin-1 and DC-SIGN
Scavenger receptors
in general the macrophage are phagocytes and express distinct PRRs: CLR-mannose, dectin, DC-SIGN
Scavenger receptor recognizes different ligands
similar to neutrophils will phagocytose and then trigger oxidative reaction
oxidative burst between macrophage and neutrophil have same result

What are the antimicrobial mechanisms of phagocytes? (Macrophage and Neutrophil)
Acidification: pH= 3.5-4.0, bacteriostatic or bactericidal
Toxic oxygen-derived products: superoxide O2-, hydrogen peroxide H2O2, singlet oxygen 1O2-, hydroxyl radical -OH, hypothalite OCl-
Toxic nitrogen oxide: nitric oxide NO
antimicrobial peptide:
Macrophage product: catheliciden, macrophage elastase-derived peptide
Neutrophil product: ⍺-defensin, β-defensin, cathlicidin, azurocidin, bacterial permeability inducing protein, lactoferricin
Enzymes:
-lysozyme: digest cell walls of some gram-positive bacteria
-acid hydrolase (e.g. elastase and other proteases): break down ingested microbes
Competitors:
Neutrophil products: lactoferrin (sequester Fe2+) vitamin B12-binding protein
What is the role of macrophages in the resolution of inflammation?
Macrophages are essential for resolving inflammation by transitioning from a pro-inflammatory () to an anti-inflammatory/pro-resolving () phenotype, facilitating the shift from acute injury to repair. They clear apoptotic neutrophils (efferocytosis), produce pro-resolving lipid mediators (e.g., resolvins, protectins), and release growth factors that stimulate tissue remodeling and return the microenvironment to homeostasis

What is the role of efferocytosis in infection and host defence?
a | Engulfment of infected apoptotic cells by macrophages leads to bacterial killing and prevents secondary necrosis of the infected cells, thereby preventing bacterial release
b| A similar pathway occurs when certain bacteria induce pyroptosis in infected cells, in which pore-induced intracellular traps (PITs) in these cells are recognized by
efferocytosis receptors
c | Other types of bacteria, such as methicillin-resistant Staphylococcus aureus (MRSA), can evade efferocytic uptake and killing by inducing expression of the don't-
eat-me signal CD47 on the cells they infect.
s. aureus picked up by neutrophils and then upregulate CD47 (popular in cancer cell- if expressed signals don’t eat me) it is recognized by SIRPa which stops the phagocytosis process
